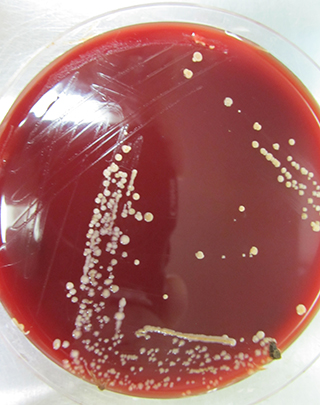

2013年2月8日

左から、牛田 京都府立大学教授、山極教授
山極寿一 理学研究科教授、牛田一成 京都府立大学大学院生命環境科学研究科教授、土田さやか 同博士課程3回生、フィリップ・ベアン ガボン共和国熱帯生態研究所研究員らの研究グループは、野生のゴリラから、これまで知られていない新菌種である可能性が高い多数のビフィズス菌を分離することに成功しました。
経過
ビフィズス菌は、人の腸内細菌の優占種の一つであり、健康の維持・促進と関係が深く、善玉菌の代表です。人間由来のビフィズス菌の研究は広く進んでおり、多くのビフィズス菌が記載されています。そして腸内環境を整えるためにビフィズス菌を利用した多くの商品が開発されており、一般社会に広く知られています。
これまで、野生のゴリラでビフィズス菌の存在は知られていなかったところ、ガボン共和国ムカラバ国立公園で実施中の山極プロジェクトで、野生のゴリラから、多数のビフィズス菌を分離することに成功しました。いずれも、これまで知られていない新菌種である可能性が高いことが判明しました。現在、大熊盛也 理化学研究所微生物材料開発室長と北原真樹 同博士の協力を得て、国際細菌命名規約に則り、新菌種として提唱中です。
単離されたBifidobacterium sp.
系統解析等から新種の可能性が高いと思われる
意義
牛田教授ら研究グループは、これまで野生や動物園等で飼育されているチンパンジーからビフィズス菌を単離してきましたが、いずれも人で存在が知られているビフィズス菌でした。今回発見されたビフィズス菌は、大きな分類では、類人猿から見つかるグループに含まれるものの、独立した一系統をなしており、これまで全く知られていない菌種でした。
ゴリラ、チンパンジーそれぞれとの共通祖先を経由して人類が進化する中で、あるグループのビフィズス菌が進化して人間の腸内に適応したと考えられます。
今回、ゴリラから見つかったビフィズス菌は、その中ではもっとも起源の古いビフィズス菌であると考えられ、類人猿の進化と腸内細菌の進化(共進化)を明らかにするうえで学術的な価値が大きいと言えます。
本研究は、研究プロジェクト:科学技術振興機構・国際協力機構 「野生生物と人間の共生を通じた熱帯林の生物多様性保全」http://www.jst.go.jp/global/kadai/h2006_gabon.html(研究代表者 山極寿一)より支援を受け、実施されました。
- 朝日新聞(2月28日 23面)、京都新聞(2月9日 27面)、産経新聞(2月19日 21面)、中日新聞(2月9日 32面)、日本経済新聞(2月9日 38面)および毎日新聞(2月9日夕刊 6面)に掲載されました。

樹上で、ムメニ(Lannea welwitschii)の実を食べる西ローランドゴリラ(Gorilla gorilla gorilla)(母親とアカンボウ)

